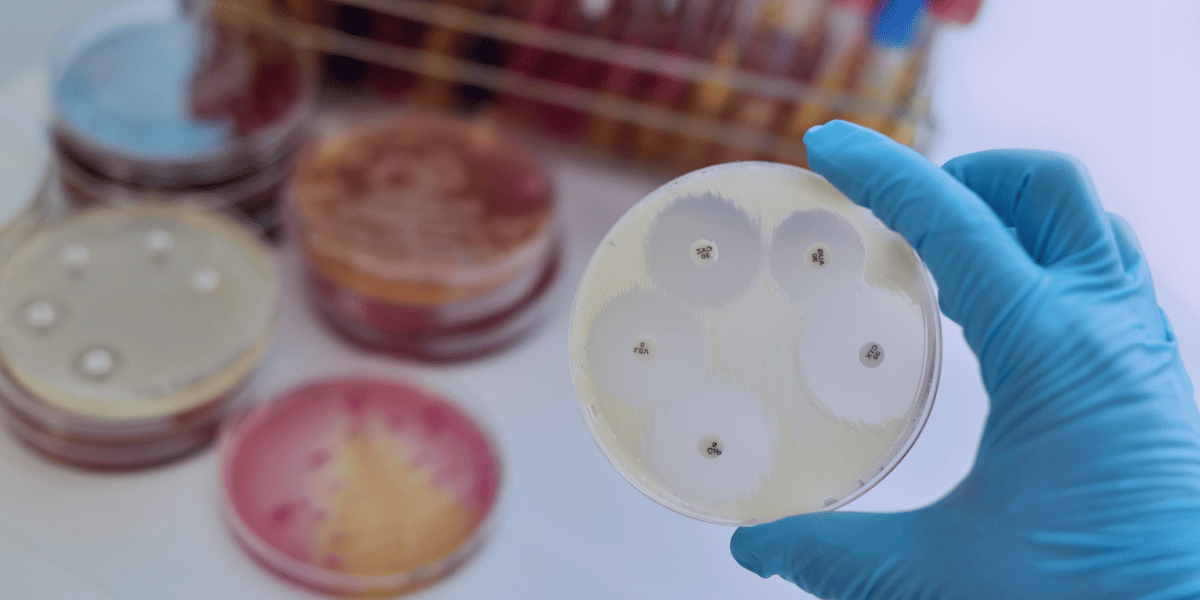
<Strong>Antimicrobials</Strong>

Empowering Sudan's Healthcare
Trusted Pharmaceutical Distibution
50 Years of excellence in delivering Life-Saving medicines, Vaccines and health Solutions

Who We Are
A cornerstone of Sudan’s pharmaceutical supply chain, with a legacy that spans over five decades. Founded in 1973 by four visionary pharmacists, PTC has evolved from a modest partnership into one of the nation’s most trusted pharmaceutical importers and distributors.
As a mission-driven organization, PTC continues to play a vital role in advancing public health outcomes and supporting the national healthcare agenda.
Our Expertise

Cardiovascular Diseases
We provide a comprehensive range of medications for managing hypertension, heart failure, and vascular conditions, supporting long-term cardiac health and reducing the burden of cardiovascular morbidity

Oncology
Our oncology portfolio includes advanced therapies that improve survival rates and quality of life for patients battling various forms of cancer

Transplantation
We supply critical impressiveness drugs essential for transplant success, ensuring patient safety and graft longevity

Endocrinology
Our offerings cover diabetes management, thyroid disorders, and hormonal therapies, supporting metabolic health and endocrine balance

Gastroenterology
We distribute treatments for digestive disorders, liver conditions, and gastrointestinal diseases, enhancing patient comfort and recovery.

Central Nervous System (CNS)
Our CNS range supports mental health, neurology, and psychiatric care, addressing conditions such as epilepsy, depression, and anxiety
Antimicrobials
We ensure access to high-quality antibiotics and antivirals to combat infectious diseases and support antimicrobial stewardship

Pain Management
Our portfolio includes analgesics for acute and chronic pain, enabling better quality of life for patients with diverse pain conditions

Dermatology
We offer dermatological solutions for skin conditions, wound care, and therapeutic skincare, supporting both medical and aesthetic needs

Ophthalmology
Our eye care products address a wide range of ocular conditions, including infections, inflammation, and vision support

Respiratory Medicine
We provide treatments for asthma, COPD, and respiratory infections, supporting pulmonary health and patient well-being
Our Partners
PTC collaborates with a curated network of globally renowned pharmaceutical manufacturers. These partnerships are built on mutual trust, regulatory excellence, and a shared commitment to improving health outcomes.
Originators & Research-Based Companies




High-Quality Generic Manufacturers








